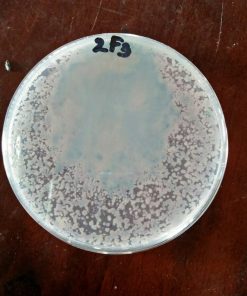
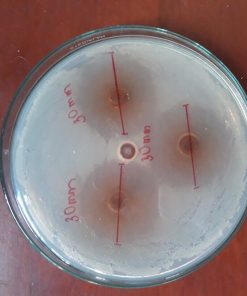

VĐ-LIVER(Gold): Thảo dược gan tạt và cho ăn hiệu quả sau 48h
Vi khuẩn Vibrio là nguyên nhân chính gây bệnh chết sớm trên tôm, chúng có khả năng sống ký sinh trong đường ruột của tôm, tiết ra độc tố làm gan tụy tôm sưng hoặc teo lại mềm nhũn gây chết hàng loạt, thậm chí 100% ao nuôi
Đối với những ao nuôi có khuẩn Vibrio Parahaemolyticus sẽ rất khó kiểm soát và khả năng tôm bị nhiễm bệnh chết sớm là rất cao. Vì thế, việc kìm hãm sự phát triển của loại vi khuẩn này trong ao là biện pháp giảm thiểu tối đa thiệt hại cho vụ nuôi.
Nắm được nguyên nhân và biểu hiện gây bệnh của Vibrio sẽ giúp người nuôi nhận biết sớm và có các hướng xử lý kịp thời. Cách tốt nhất, bà con nên phòng bệnh ở tôm giống và tôm nhỏ (bằng các chế phẩm sinh học, chiết xuất thảo dược dưỡng gan) thay vì đợi đến khi nhiễm bệnh mới xử lý vì thiệt hại sẽ rất lớn



 English
English

Đánh giá
Chưa có đánh giá nào.